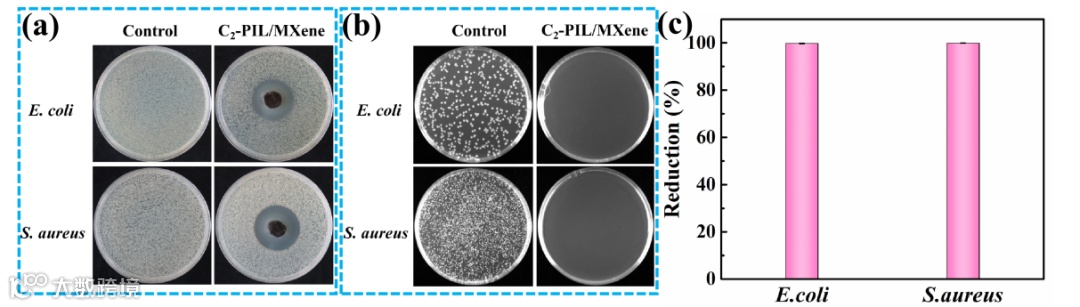

近日,华中科技大学强电磁工程与新技术国家重点实验室/电气与电子工程学院赵龙教授团队利用电离辐射技术成功制备出基于聚(离子液体)/MXene凝胶的多功能柔性应变传感器,相关研究成果发表于国际知名期刊Chemical Engineering Journal上。
柔性应变传感器(FSSs)可以将来自外界刺激的机械信号转换为实时电信号,因而在人体运动、健康监测、人机界面和软机器人等领域被广泛研究。导电水凝胶因其制备简单、柔韧性高、导电性好、自愈能力强等优点得到了广泛的研究。然而,水凝胶衍生的FSSs通常具有较差的耐温性和相对狭窄的电化学窗口,严重限制了进一步的实际应用。尽管许多研究人员尝试使用低挥发性有机溶剂制备的有机凝胶代替水凝胶作为传感材料来解决上述问题,但有机凝胶往往表现出相对较低的电导率和灵敏度。因此,如何制备同时兼具高灵敏度和导电性、优异的环境耐受性、柔性可调等优点的高性能FSSs导电材料是一项极具挑战的任务。
近年来,聚离子液体(PILs)凝胶作为一种新型的先进材料,因其具有高导电性、极低挥发性、可调节的物理化学性质以及良好的热稳定性和化学稳定性而备受关注。将PILs引入有机凝胶有望改善有机凝胶的导电性和灵敏度。值得注意的是,PILs还会赋予有机凝胶增强的抗菌能力和更好的抗冻性,使其成为许多软电子器件的潜在候选者。然而,目前只有少数研究报道了基于PILs的有机凝胶,而且这些有机凝胶主要通过非共价相互作用构建,导致其力学性能和稳定性较差。
二维(2D)过渡金属碳化物/氮化物(Ti3C2Tx MXene)作为一种新型的二维纳米材料,具有高的化学稳定性、柔韧性、优异的导电性和机械强度,在FSSs中显示出很高的应用潜力。此外,MXene表面丰富的活性基团(-OH,-F和=O)可以和聚合物基体之间形成丰富的非共价交联作用,从而提高凝胶的机械性能和导电性。
1.针对上述问题,本工作提出了增加凝胶中的非共价作用以及在交联结构中引入共价/非共价协同作用机制来提高和改善凝胶的机械性能,稳定性和导电性的思路。本工作使用含有-C=C-双键的咪唑类ILs分别作为单体和交联剂,Ti3C2Tx MXene同时作为物理“交联剂”和导电纳米填料,首次采用电离辐射技术诱导离子液体单体在有机溶剂中发生辐射聚合/交联,一步法原位制备出一系列兼具共价和非共价交联结构的双交联新型聚(离子液体)/MXene(Cn-PIL/MXene)凝胶。
2.本工作系统研究了不同碳链长度的咪唑ILs单体的凝胶化机制及其凝胶性能。结果表明, 含有较短烷基侧链的IL形成的凝胶(C2-PIL/MXene)具有更好的拉伸性(≈600%)、良好的导电性(4.9 mS cm−1)、快速的自愈能力(<8 min)、优异的粘附性(266.9 kPa)和快速的响应时间(<100 mS)。此外,所制备的C2-PIL/MXene凝胶还具有优异的抗冻性能(−60 ℃)、环境耐受性(90天)和优异的抗菌活性(抗菌率:大肠杆菌(99.82%),金黄色葡萄球菌(99.98%)。
3.基于C2-PIL/MXene凝胶的多功能柔性应变传感器,能够实时快速的响应人体的各种活动,识别书写笔画,实现信息的加密传输,在柔性智能可穿戴设备中显示出巨大的应用潜力。
4.本工作利用辐射技术建立一种简便高效,绿色环保,且可望规模化制备用于柔性电子器件的高性能聚离子液体凝胶复合材料的新方法。




图4. Cn-PIL/MXene凝胶的机械性能和自愈合性能




相关成果以“Radiation synthesis of rapidly self-healing, durable, and flexible poly(ionic liquid)/MXene gels with anti-freezing property for multi-functional strain sensors”为题发表在Chemical Engineering Journal(DOI:10.1016/j.cej.2023.143660)上。华中科技大学化学与化工学院博士研究生赵文超为本论文的第一作者,通讯作者为华中科技大学强电磁工程与新技术国家重点实验室/电气与电子工程学院赵龙教授。感谢国家自然科学基金(11875138)和华中科技大学分析测试中心。
原文链接:
https://doi.org/10.1016/j.cej.2023.143660
相关进展
华科大赵龙教授团队 CEJ:具有光/电热转化能力的镓掺杂MXene/纤维素纳米纤维复合薄膜用于高效电磁屏蔽
苏大李刚教授、英国曼大李翼教授和牛津大学刘泽堃博士合作 AFMs: 牛角瓜纤维基可穿戴柔性应变传感器
中国石油大学(华东)张冬至教授团队 ACS AMI:机器学习助力柔性应变传感器用于运动检测及其文字识别
天工大杨光/闫静/庄旭品《ACS AMI》:基于层级碳纳米纤维的类皮肤柔性应变传感器

高分子科技原创文章。欢迎个人转发和分享,刊物或媒体如需转载,请联系邮箱:info@polymer.cn

欢迎专家学者提供稿件(论文、项目介绍、新技术、学术交流、单位新闻、参会信息、招聘招生等)至info@polymer.cn,并请注明详细联系信息。高分子科技®会及时推送,并同时发布在中国聚合物网上。
欢迎加入微信群 为满足高分子产学研各界同仁的要求,陆续开通了包括高分子专家学者群在内的几十个专项交流群,也包括高分子产业技术、企业家、博士、研究生、媒体期刊会展协会等群,全覆盖高分子产业或领域。目前汇聚了国内外高校科研院所及企业研发中心的上万名顶尖的专家学者、技术人员及企业家。
申请入群,请先加审核微信号PolymerChina(或长按下方二维码),并请一定注明:高分子+姓名+单位+职称(或学位)+领域(或行业),否则不予受理,资格经过审核后入相关专业群。